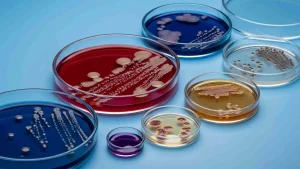
alt="شناسایی سودوموناس آئروژینوزا روی محیط Cetrimide Agar | تولید پیگمان سبز-آبی فلورسنت در تست افتراقی نیکوفارمد | آزمون اکسیداز مثبت"

تست افتراقی چیست؟
تست افتراقی (Tests for Specified Microorganisms) یک روش آزمایشگاهی است که به کمک آن تفاوتهای بیوشیمیایی، سلولی یا مورفولوژیکی بین نمونهها شناسایی میشود. این تستها باعث میشوند بتوانیم انواع باکتریها، سلولها یا واکنشهای متفاوت را از هم تشخیص دهیم، مثلاً با رنگ، شکل کلنی یا تفاوت در رشد و فعالیت آنها.
طبق USP 〈62〉 برای بررسی وجود یا عدم وجود میکروارگانیسمهای مشخص در نمونه های غیراستریل و برای جستوجوی ارگانیسمهای مشخص از جمله Staphylococcus aureus، Pseudomonas aeruginosa، Escherichia coli، Salmonella spp، باکتریهای گرممنفیِ مقاوم به صفرا و Candida albicans تست افتراقی انجام می شود و در نهایت نتیجه بهصورت حضور/عدم حضور گزارش میشود.
در مقابل، شمارش بار میکروبی USP 〈61〉 (Microbial Enumeration Tests) است که بهطور کمی TAMC (کل شمارش هوازیها) و TYMC (کل مخمر و کپک) را در شرایط هوازی اندازهگیری میکند و حدود پذیرش فرآوردههای غیراستریل در USP 〈1111〉 تعریف شدهاند. بنابراین در USP 〈62〉 علاوه بر شمارش میکروارگانیسمها، جستوجو و تأیید حضورشان انجام میگیرد.
جهت دریافت خدمات و مشاوره رایگان با نیکوفارمد تماس بگیرید.
تست افتراقی چگونه انجام می شود؟
آمادهسازی نمونه و خنثیسازی
مقداری فرآورده (معمولاً ۱۰ گرم/میلیلیتر) در رقیقکننده/محیط غیرانتخابی مناسب (مانند TSB یا پپتون بافری) معلق میشود. در صورت وجود عوامل ضدمیکروبی، از خنثیکنندههای تأییدشده (مانند لستیتین، پلیسوربات ۸۰ و غیره) استفاده میشود تا اثر مهاری ماتریس کنترل گردد.
غنیسازی غیرانتخابی (Pre-enrichment)
سوسپانسیون تهیهشده در شرایط باکتریایی (تقریباً ۳۰–۳۵ °C) و قارچی (۲۰–۲۵ °C) برای مدت زمان مقرر انکوبه میشود تا امکان بازیابی میکروارگانیسمهای آسیبدیده یا کمشمار فراهم گردد.
غنیسازی/کشت انتخابی و افتراقی
از کشت غنیشده به محیطهای انتخابی/افتراقی انتقال داده میشود و برای هر ارگانیسم هدف مسیر استاندارد دنبال میشود، از جمله:
Staphylococcus aureus: کشت روی Mannitol Salt Agar و انجام آزمونهای تأییدی (مانند کوآگولاز).
Pseudomonas aeruginosa: کشت روی Cetrimide Agar، بررسی اکسیداز و تولید پیگمان.
Escherichia coli: کشت روی محیطهای لاکتوزی (مانند MacConkey) و تأیید بیوشیمیایی (الگوی IMViC یا معادل).
Salmonella spp.: پیشغنیسازی در Buffered Peptone Water، غنیسازی انتخابی (مانند Rappaport-Vassiliadis و/یا تترا تیونات)، سپس جداسازی روی XLD/Hektoen/Bismuth Sulfite و تأیید اختصاصی.
باکتریهای گرممنفی مقاوم به صفرا (Enterobacteriaceae): غنیسازی در Enterobacteria Enrichment Broth
(Mossel) و کشت روی VRBG Agar با تأییدهای لازم.
Candida albicans: کشت روی محیطهای قارچی (مانند Sabouraud Dextrose Agar) و آزمونهای تأییدی (مانند جوانهزنی یا شاخصهای فنوتیپی معتبر).
انکوباسیون و پایش رشد
صفحات/لولهها در دماهای توصیهشده و بازههای زمانی استاندارد انکوبه میشوند. مشاهده کلنیهای «مشکوک» مبنای ورود به مرحله تأیید تست افتراقی است.
تأیید هویتی (Confirmatory Identification)
کلنیهای مشکوک با آزمونهای بیوشیمیایی/فیزیولوژیک یا روشهای شناسایی معتبر (مانند سیستمهای اتوماتیک یا تاییدهای مولکولی در صورت نیاز) بررسی و هویت آنها نسبت به اهداف فصل احراز میشود.
ارزیابی کفایت روش (Method Suitability/Test Recovery)
بهطور موازی، کفایت روش با تلقیح مقادیر کم (∼۱۰–۱۰۰ CFU) از سویههای مرجع برای هر ارگانیسم هدف در حضور ماتریس نمونه انجام میشود تا نشان داده شود خنثیسازی و کل روش قادر به بازیابی ارگانیسمها است. کنترلهای مثبت و منفی باید نتایج قابلقبول ارائه دهند.
معیار پذیرش و گزارشدهی
در این بخش از تست افتراقی خروجی بهصورت حضور/عدم حضور برای هر میکروارگانیسم هدف گزارش میشود. در صورت مشاهده/تأیید هر یک از اهداف، نتیجه «نامقبول» اعلام می شود.
مستندسازی و ردیابی
شماره استاندارد آزمون، شمارههای بچ نمونه ها، شرایط انکوباسیون، مشاهدات و نتایج مستندسازی و قابل ردیابی هستند.
جهت کسب اطلاعات بیشتر در رابطه با آزمون بایوبردن کلیک کنید.
مقایسه تست شمارش میکروبی USP 〈61〉 و آزمون افتراقی USP 〈62〉
| محور مقایسه | USP 〈62〉 – Tests for Specified Microorganisms | USP 〈61〉 – Microbial Enumeration Tests |
|---|---|---|
| هدف | جستوجوی وجود/عدم وجود میکروارگانیسمهای «مشخص» | شمارش کمی جمعیت میکروبی کلی |
| ماهیت نتیجه | کیفی (Presence/Absence) برای هر ارگانیسم هدف | کمی (CFU/g یا CFU/mL)؛ گزارش TAMC و TYMC |
| دامنه کاربرد | فرآوردههای غیراستریل برای رد حضور پاتوژن/شاخصها | فرآوردههای غیراستریل برای برآورد بار میکروبی کلی |
| ارگانیسمهای مورد نظر | S. aureus، P. aeruginosa، E. coli، Salmonella spp.، باکتریهای گرممنفی مقاوم به صفرا (Enterobacteriaceae)، Candida albicans | گروه خاصی هدف نیست؛ کل باکتریهای هوازی مزوفیل (TAMC) و مخمر/کپک (TYMC) |
| طرح آزمایش | پیشغنیسازی غیرانتخابی → کشت روی محیطهای انتخابی/افتراقی → تستهای تأییدی هویتی | رقیقسازی/کشت روی محیطهای غیرانتخابی استاندارد → شمارش کلنیها |
| پذیرش/حدود | وجود هر ارگانیسم هدف = عدم انطباق (مگر استثنای مونوگراف) | حدود مجاز عددی بر اساس نوع محصول (ارجاع به 〈1111〉) |
| کفایت روش (Method Suitability) | الزامی برای هر ارگانیسم هدف در ماتریس نمونه | الزامی برای اثبات خنثیسازی/عدم مهار و صحت شمارش |
| کنترلها | کنترلهای مثبت/منفی اختصاصی برای هر هدف | کنترلهای مثبت/منفی عمومی برای شمارش |
| خروجی گزارش | «مشخص شد/نشد» برای هر ارگانیسم هدف | TAMC و/یا TYMC با واحد CFU و تفسیر نسبت به حدود |
| کاربرد معمول | ایمنی میکروبی و انطباق با الزامات عدم حضور پاتوژن | ارزیابی کیفیت بهداشتی/پایداری و روندهای فرایندی |
آزمایشگاه همکار نیکوفارمد، با برخورداری از گواهینامه معتبر ISO/IEC 17025 و استقرار نظام تضمین کیفیت مبتنی بر الزامات بینالمللی، توان اجرای آزمون افتراقی میکروارگانیسمهای مشخص طبق استاندارد USP 〈62〉 را بهصورت مستند و قابل ردیابی دارد. این آزمایشگاه با بهکارگیری روشهای تأییدشده (Method Suitability)، کنترلهای مثبت و منفی، و استفاده از محیطهای انتخابی/افتراقی اختصاصی، حضور یا عدم حضور میکروارگانیسمهای هدف را ارزیابی و نتیجه را مطابق الزامات کیفی گزارش میکند. بهرهگیری از تجهیزات کالیبره، پرسنل آموزشدیده و رویههای استاندارد عملیاتی (SOP) تضمین میکند که نتایج با دقت، تکرارپذیری و قابلیت اتکا ارائه شوند.